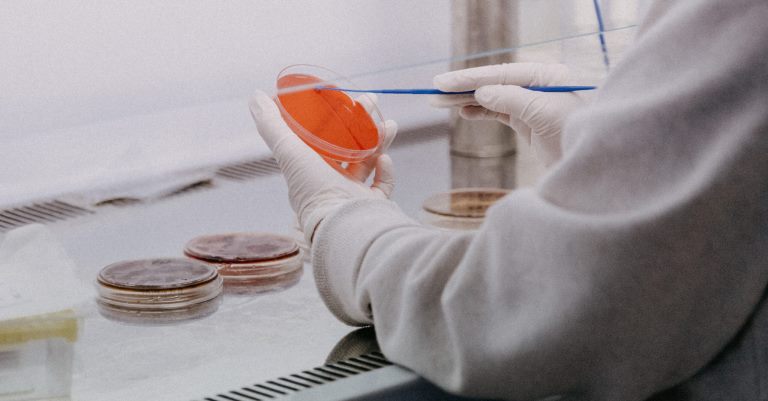

ANZGOG continues to achieve significant milestones by expanding innovative treatment trials and pre-clinical research, collaborating closely with our valued supporters and members, and strengthening our sector through advocacy and education.
This year we opened four studies to recruitment for women with ovarian and endometrial cancer; XPORT-EC-042, EN.10/TAPER, DOMENICA and RAMP.301, and reached significant milestones with two trials in follow-up after completing recruitment. We express our heartfelt appreciation and thanks to all participating women and their families, the participating hospitals and collaborating trial teams for their long-term commitment to these studies. ANZGOG is fortunate to have 1,457 members working locally and globally to improve outcomes for everyone with a lived experience of gynaecological cancer.
In April we held our 2024 Annual Scientific Meeting (ASM) in New Zealand, Aotearoa for the first time and attracted the largest face-to-face attendance at an ANZGOG ASM. 339 delegates came together in Wellington NZ to discuss ‘Breaking Down Barriers in Gynaecological Cancer Care’, shining a light on the cultural, socioeconomic and regional diversity of our patients and highlighting many opportunities for improving equity of access to research and care.
Once again this proved to be an outstanding opportunity for early career researchers and specialist members to attend the ASM and meet with leaders in gynaecological oncology, both nationally and internationally. Delegates were fortunate to hear from three significant international speakers from the UK and France at the conference, who all delivered inspiring keynote addresses.

















ANZGOG members published in the Lancet

WomenCan Larapinta trek 2023
Three dedicated ANZGOG members and a a diverse group of WomenCan supporters, including people with a lived experience of gynaecological cancer took on the Larapinta trek to fundraise for ANZGOG’s research. Together, they raised $75,000 - a fantastic achievement.

Cervical and Vulvar Cancer Foundation Series 2023
ANZGOG's third Foundations Education Series webinar on Cervical and Vulvar Cancers, held in September and supported by AstraZeneca, featured 15 expert presenters covering diverse topics and was attended by 252 health professionals, including international participants.

World GO Day webinar
Lunch and Learn webinar held for Gynaecological Cancer Awareness Month.

ROSELLA activates first site
The ROSELLA study, looking at the use of Relacorilant in combination with Nab-Paclitaxel in advanced high-grade ovarian cancer, activates it’s first site at Peter MacCallum Cancer Centre

Research Development Day
80+ members attend and actively engage in the research development day

Community Engagement Program launches on International Volunteers Day
ANZGOG’s Community Engagement Program delivers opportunities for people with lived experience of gynaecological cancers to contribute meaningfully and fosters a groundswell of action through our volunteers, to impact outcomes for women now and in the future. Volunteer opportunities exist across education, advocacy and research.

ANZGOG awards $175,000 to four member research projects
ANZGOG awarded funds to A/Prof Kylie Gorringe, A/Prof Emma Allanson, Dr Marilyn Boo and A/Prof Alison Davis for pioneering research in gynaecological cancers in the Fund for New Research Grant round 2023. Funded through philanthropy and public donations, this grant aims to stimulate the development of future clinical trials.
Stronger together at the parliamentary breakfast
The CEOs of ANZGOG, Ovarian Cancer Research and Ovarian Cancer Australia attended OCA’s Teal Ribbon Parliamentary Breakfast on 6 Feb.
All three organisations are committed to working and advocating together to ensure ovarian cancer is a national priority. We are stronger together.


Assoc Prof Yoland Antill, presents poster on the PHAEDRA study at ESGO 2024
Assoc Prof Yoland Antill, Deputy Chair of ANZGOG's Research Advisory Committee, presenting a poster on the PHAEDRA study at ESGO 2024.
The PHAEDRA trial examined the activity of an immunotherapeutic agent in women with advanced endometrial cancer that were either dMMR or pMMR.
EN.10/TAPER trial opens
The EN.10/TAPER study is open to recruitment in eight Australian sites and one site in New Zealand. This trial explores ways to treat early-stage endometrial cancers with a focus on minimising side effects and costs. The goal of this trial is to change and inform practice, leading to less toxicity for patients and better utilisation of health care resources internationally.
Lead by PI Alison Brand

ANZGOG 2024 Annual Scientific Meeting
For the first time our ASM was held in New Zealand and 339 delegates attended. The theme was “‘Breaking Down Barriers in Gynaecological Cancer Care”.

2024 ANZGOG awards
Five outstanding individuals were recognised in the 2023 ANZGOG Awards for their outstanding contributions to gynaecological cancer research. Their work continues to make a real difference in the lives of people affected by gynaecological cancer.

First patient recruited for EN.10/TAPER
The first Australian patient for the endometrial cancer trial was enrolled at Westmead Hospital

This year represented another successful year for ANZGOG’s research portfolio, with four trials opening to recruitment, two completing recruitment, and several new trials under development or poised to commence recruitment in 2024/25. Our members continue to show commitment and dedication, helping us to advance pioneering gynaecological cancer research and continue to improve outcomes for women.

ANZGOG was pleased to open four studies this year.

During 2023-2024, ANZGOG successfully attained numerous recruitment benchmarks, enabling two studies to close to recruitment and move into the next stage. ANZGOG extends its profound gratitude towards all the women and their families who participated in the studies. Without them, we would not be able to advance research to improve patient outcomes.
Patient Recruitment: 36/80
Sites Open: 3/4
For Cohort: 3
Patient Recruitment: 12
Sites Open: 8
Patient Recruitment: 57/135
Sites Open: 16
Patient Recruitment: 254/760
Sites Open: 10
Patient Recruitment: 1
Sites Open: 3
Patient Recruitment: 0
Sites Open: 2
Patient Recruitment: 0
Sites Open: 0
Patient Recruitment: 4/73
Sites Open: 3/3

ANZGOG congratulates A/Prof Kylie Gorringe, A/Prof Emma Allanson, Dr Marilyn Boo and A/Prof Alison Davis for their success in the Fund for New Research Grant round in 2023.
There were 18 submissions for the 2023 Fund for New Research. Each application underwent assessment by two evaluators and deliberation at the ANZGOG Research Advisory Committee (RAC). All submissions endorsed by the RAC were appraised by the Panel for the Fund for New Research and evaluated based on clinical or pre-clinical investigations criteria. The recommended priority projects were ultimately examined and approved by the ANZGOG Board.
The Fund for New Research is made possible by contributions from the public, legacies, and philanthropic grants from organisations with shared interests in ANZGOG's research endeavours. Thanks to this backing, ANZGOG has funded 22 studies from 2015 to 2023 inclusive.
This financial year saw TR-ANZGOG implemented into its first ANZGOG trial, EPOCH. This important trial in the particularly rare, aggressive tumour type carcinosarcoma (uterine and tubo-ovarian) is underpinned by strong pre-clinical (laboratory-based) research. EPOCH’s contemporary clinical trial design requires complex biospecimen collection to maximize research outcomes, which has been facilitated through TR-ANZGOG support.
Additional TR-ANZGOG Network Laboratories were approved, to include representation in regional New South Wales and New Zealand. TR-ANZGOG Network Laboratories are currently supporting recruiting ANZGOG trials, PARAGONII and EN.10, and the TR aspects of OUTBACK, now closed to recruitment. This support includes tissue microarray construction, creating a valuable resource to enable future research.
SOLACE2 provided a pilot study for the TR-ANZGOG research initiative with the translational research aspects managed by TR-ANZGOG. The final patient visit for SOLACE2 is scheduled for 31 July 2024. The successful collection of over 1800 blood and tissue samples across 15 Australian sites, processed centrally in Melbourne, is an outstanding achievement and provided a wealth of learnings!
TR-ANZGOG will focus on data management infrastructure to ensure the secure storage of data associated with biospecimens to facilitate future research, including the return of research results to further build our knowledge and generate trial development.
The Patient Referral Network Project aims to create a coordinated referral system that ensures patients with gynaecological cancers in Australia and New Zealand have access to the latest clinical trials through ANZGOG's research program. By connecting regional hospitals and healthcare centres with metropolitan clinical trial units, the project seeks to improve equity in access, enabling patients in regional and rural areas to receive innovative treatments closer to home. Special attention is given to First Nations and Culturally and Linguistically Diverse (CALD) populations, optimizing care within their communities and addressing unique needs to enhance engagement and participation in clinical trials.
The project's initial phase involved a comprehensive site capacity and capability survey, completed by over 90% of ANZGOG’s affiliated sites. This data, stored in a central database, is instrumental in optimizing clinical trial site selection and developing tele-trial models to reach underserved regions. Future priorities include addressing barriers to participation for Indigenous and CALD populations, promoting culturally appropriate communication resources, and embedding tele-trial approaches into ANZGOG’s research studies. These efforts aim to empower diverse patient populations to discuss clinical trials openly with their families and healthcare teams, fostering greater inclusion and engagement.
Our membership has grown significantly since our organisation was founded in 2000, more than doubling in the last eight years to just short of 1,457. ANZGOG's members in every Australian state and New Zealand are dedicated to growing the research portfolio in both treatment, surgery, radiation oncology, quality of life and survivorship. Together with our staff, donors and partners, our members work to improve life for everyone with a lived experience of gynaecological cancer through cancer research.









ANZGOG’s 1,457 members are based at over 86 hospitals, universities and research institutions in Australia and New Zealand. These members volunteer their time to help operate the organisation and take part in tumour working groups, research and advisory committees.
The diagram below represents how some committees feed into the Research Advisory Committee. A full organisational governance chart can be found here.
The SCC had a brilliant start to the year, hosting the SCC workshop in New Zealand for the first time. Dr Helen Wihongi spoke to the protection of Māori women’s cervical screening data, giving insight to the Australian representatives, many of whom were unfamiliar with the cultural aspects of healthcare in the nation. We were lucky enough to also join the nurses cohort, listening to several patient stories and returning to workshop our learnings on diversity and inclusion in the light of the new Australian national clinical governance framework.
Kathyrn Jenkins officially retired from the committee earlier this year and we would all like to thank her for her incredible leadership and contribution to the committee over the past 6 years. Maddy Williams, our New Zealand representative also resigned, and we wish her luck on her overseas adventures. Dr Meghan Leigh will complete her term as chair in January 2025 and we’re happy to announce that Sally Montga will step into the Chair role, supported by Rachel Rowse as chair elect. We also welcomed three new members, Aaina Sanon (Auckland City Hospital, NZ), Kate Campbell (Westmead Hospital, NSW) and Peyman Rezaie (Canberra Hospital, ACT), ensuring we have a broad representation over all of our sites.
We have been hard at work this year compiling a new online resource pack for support of new and current Study Coordinators across Australia and New Zealand, which will be included in the new member portal on the ANZGOG website and look forward to welcoming members to our workshop at the 2025 ASM in Canberra.

Dr Meghan Leigh
Chair - Study Coordinator Committee
The Uterine Tumour Working Group (UTWG) aims to support ANZGOG members in the development of novel clinical trials in endometrial cancer. Cases of endometrial cancer, which accounts for 90-95% of uterine cancer cases, are rising rapidly around the globe. In Australia, case numbers have doubled over the last 20 years, whilst in New Zealand numbers have trebled.
In 2024, I took over as Chair of the UTWG from Caroline Ford. I am grateful to Caroline for her leadership of the group and mentorship. The UTWG includes medical oncologists, radiation oncologists, surgeons, statisticians and translational scientists who all contribute to active discussions and feedback on trial ideas and pre-clinical research leading to trials. Recently we have welcomed new consumer research advisers and look forward to their ongoing contributions. This year the group has supported the development of a study investigating the feasibility of a combined exercise and nutrition ‘prehabilitation’ program for patients with endometrial cancer prior to surgery, led by Associate Professor Emma Allanson. This study is now open and recruiting patients. The group has also supported idea generation in a number of other areas with some exciting concepts in the early phases of clinical trial development.

Dr Janine Lombard
Chair – Uterine Tumour Working Group
The Cervical, Vulva Vaginal Tumour Working Group (CVVTWG) scope is to foster new concepts and research ideas with the aim of improving outcomes for women with these gynaecological subtypes, primarily related to the Human Papilloma Virus (HPV).
The past 18 months has been an incredibly interesting time and notably potentially practice changing breakthroughs in the definitive management of locally advanced cervical cancer and recurrent disease on the international front. This has raised many interesting questions on its impact and future directions in this space. In line with this, in addition to hosting a multidisciplinary education series and preceptorship in cervical cancer and vulval cancer in the second half of 2023 , our group has continued to work towards bringing forth new concepts from pre- invasive to advanced disease as well as research initiatives aimed at measuring and improving quality of life of patients affected by these diseases despite the often challenging funding environment.
As I step down as Chair of the CVVTWG, I would like to thank the committee as well as ANZGOG for their continued help and enthusiasm and look forward to supporting Felicia Roncolato who will step into the role as chair from 2025.

Dr Ming Yin Lin
Chair – Cervix, Vulva, Vaginal Tumour Working Group
The role of the Ovarian Tumour Working group (OTWG) is to support and guide the direction of the research in ovarian cancer within the organisation. It enables access to expertise across the spectrum of patient care to help develop an idea from a concept to a trial. It provides external input to help ensure the research is of the highest scientific quality and is relevant to people across Australia and New Zealand. The OTWG is composed of members with a breadth of experience in gynaecological cancer clinical trials, including clinicians from gynaecologic oncology, medical oncology and radiation oncology, basic and translational scientists, a Quality of Life expert, and consumer representatives.
2024 has shown activity continues to grow upon the success of previous years. ANZGOG has five clinical trials open to recruitment during this period – HyNOVA, MOST Follow Up, IGNITE, EPOCH and PARAGON-II. We have seen results of previous studies we have been involved with presented at ESMO this year.
We are excited to see ANZGOG’s research portfolio in ovarian cancer continue to grow with an increasing number of promising concepts presented across the continuum of patient care. The growing collaborations between scientists and clinicians in this space highlights the core basis of the organisation and underpin the core values of ANZGOG whilst emphasising the potential for more growth as we look to 2025. I have really enjoyed my time as chair of this committee and look forward to being part of this inspirational committee as an ongoing member. I would like to thank A/Prof Kylie Gorringe for her invaluable support as Chair Elect over the past year.

Dr Michelle Wilson
Chair - Ovarian Tumour Working Group
The Research Advisory Committee (RAC) makes recommendations on ANZGOG’s research priorities and decides which trial concepts and protocols are supported for development, based on their scientific quality and importance. The RAC also oversees the progress of clinical trials including reviewing reports from principal investigators and trial management committees.
The RAC embodies ANZGOG’s truly multidisciplinary membership, representing sub-specialities in gynaecological oncology and regions of Australia/New Zealand where clinical trials are conducted. The RAC includes clinicians from Gynaecologic Oncology, Medical Oncology and Radiation Oncology, basic and translational scientists, Quality-of-Life experts, Nurses, Biostatisticians, and people with lived experience, and we are immensely grateful to them for their time and expertise. Associate Professor Yoland Antill, Deputy Chair of the RAC, deserves special mention for her incredible support providing knowledge and insight.
Research highlights of 2024 include two new trials opening to recruitment – DOMENICA and XPORT-EC-042, and a third arm of IGNITE opening to recruitment thereby becoming ANZGOG’s first platform study. Additional trials currently recruiting include ANVU, ADELE, EN.10/TAPER, ENDO-3, EPOCH, PEACE, and PARAGON-II. There is a healthy pipeline of trials in development, both homegrown and international collaborations. ANZGOG also submitted its highest number of grants (10) as an Administering Institution in 2024 and we are hopeful that a mix of government/philanthropic granting opportunities with our Industry-supported trials will see the research portfolio go from strength to strength into 2025.

Professor Paul Cohen
Chair – ANZGOG Research Advisory Committee


The ANZGOG Cervical and Vulvar Cancers Preceptorship was held 8 & 9 December and chaired by Prof Paul Cohen (GO, WA) and Dr Ming-Yin Ling (RO, VIC). In total, 22 mentors and 19 mentees participated in this educational program, and a further 38 fellows, trainees, registrars and early career clinicians attended the online session. We also had a consumer share her lived experience with a vulvar cancer diagnosis.
This was a great opportunity for the participants to understand the landmark studies and discuss clinical practice in cervical and vulval cancers, with experts in Australia and New Zealand, and an excellent learning opportunity for the fellows and trainees who presented, including valuable discussions by the mentors and guest panellists.
ANZGOG, as part of its member education activities, presented the third of its Foundations Education Series, focusing on Cervical and Vulvar Cancers for ANZGOG members and others across the health sector. The Cervical and Vulvar Cancers Webinar was held on the 4 and 8 of September and was co-Chaired by A/Prof Pearly Khaw and Dr Felicia Roncolato. Fifteen renowned ANZGOG members, all leaders in their fields, presented on the following topics and more: Cervical Cancer Prevention, histopathology of Cervical Cancer, Cervical Cancer staging, surgical management of cervical cancer, adjuvant treatment of cervical cancer, metastatic treatment, epidemiology, staging and histopathology of vulvar cancer, management of locally advanced vulvar cancer, sexual health, and treatment of early menopause.
This educational webinar was attended by 252 members including some of ANZGOG’s international colleagues. This Foundations in Gynaecological Cancers Series has been supported by AstraZeneca since 2021.


People with a lived experience of gynaecological cancers are the centre of everything ANZGOG does. Gynaecological cancer survivors and caregivers are in a unique position to share personal insights to shape future directions in gynaecological cancer research, advocate for research funding and educate the next generation of health professionals. Throughout 2023-24, ANZGOG designed and developed a Community Engagement Program that provides opportunities for people with a lived experience of gynaecological cancer to contribute meaningfully and fosters a groundswell of action to impact outcomes for women now and in the future.
Development of the Community Engagement Program was informed by extensive consultation with stakeholders, ANZGOG members, community volunteers and organisations with significant experience in consumer partnerships. The Program provides opportunities for people with a lived experience of gynaecological cancer to contribute across three pillars: Education (Survivors Teaching Students*), Advocacy and Research – based upon individual areas of interest, or expertise, by matching volunteers with the pillar most suited to them.
The design of the Community Engagement Program ensures ANZGOG’s strategies, priorities and activities are informed by, and reflect, the diverse needs of people with a lived experience of gynaecological cancer.
ANZGOG’s Advocacy pathway is designed to highlight the importance of gynaecological cancer research and critical gaps in research funding.
By joining the Advocacy volunteer pathway, individuals have the opportunity to use their lived experience to emphasise the importance of investing in research, ultimately contributing to saving lives and empowering women.
Survivors Teaching Students (STS) is a ground-breaking volunteer program that brings gynaecological cancer survivors and caregivers into the classrooms of health professional students to teach them about women’s experiences with the diseases.
Since the commencement of STS in 2017, over 18,000 students in Australia and New Zealand have gained a deeper understanding of gynaecological cancers to take into their future practice through this initiative.
*The Survivors Teaching Students program is under license to ANZGOG from the Ovarian Cancer Research Alliance in the USA.
Research Community Volunteers contribute to ANZGOG research at every stage of the development process.
Community volunteers lend their voices to research discussions sharing their personal perspective and representing the broader views of people with lived experience of gynaecological cancer.

active volunteers involved in ANZGOG’s Community Engagement Program

new volunteers joined the Survivors Teaching Students (STS) program

in-person training workshop held for the New Zealand STS Team

community volunteers recruited for roles across the Research Pillar

community volunteers supported to attend the ANZGOG 2024 ASM in Wellington

STS education sessions delivered reaching 3850 students

University Partners worked with to deliver the STS program.
Including 15 medical schools, 11 nursing schools, and opportunities to engage with medical science and allied health students.
ANZGOG actively engages with our members, the Australian and New Zealand clinical research community and our international partners to ensure the relevance, vibrancy and impact of our research agenda. ANZGOG collaborates with organisations with a similar agenda to address shared challenges. These collaborations are the key to ANZGOG’s success and support our diverse research activity and our work as a leader in gynaecological cancer research.
The ANZGOG 18th Annual Scientific Meeting (ASM) was held in New Zealand, Aotearoa for the first time on 22 – 24 April 2024, and attracted the largest-ever face-to-face attendance at an ANZGOG ASM.
339 delegates came together in Wellington to discuss the groundbreaking theme ‘Breaking Down Barriers in Gynaecological Cancer Care’, shining a light on the cultural, socioeconomic and regional diversity of our patients and highlighting many opportunities for improving equity of access to care.
The conference began with a range of diverse and engaging workshops for early-career researchers, scientists, radiation oncologists, gynae-onc nurses, study coordinators, and consumers engaged in clinical trial research exploring the theme of diversity and equity. Yet again this proved to be an outstanding opportunity for early career researchers to attend this meeting and meet with leaders in gynae oncology, both nationally and internationally.

The main conference featured inspiring keynote addresses by acclaimed international speakers:

Prof Emma Crosbie (U.K.)
Preventing obesity driven endometrial cancer

Dr Gemma Eminowicz (U.K.)
Optimising outcomes for locally advanced cervical cancer in the real world

Prof Isabelle Ray-Coquard (France)
French Rare Gynaecological Cancer Network: a strategy to improve outcomes in rare tumour groups
The Pure Science Symposium, held on the first day of the conference - now a staple of the ANZGOG ASM program – matches pure scientists with clinical researchers to ensure that the findings in the lab are translated to clinical trial development. This is truly an incubator for gynaecological cancer clinical trials.
Pre-clinical Abstract Award
Nikki Burdett
Clinical Abstract Award
Jennifer Davies
Pre-clinical Poster Award
Nicola Meagher
Clinical Poster Award
Julia Matas



The Gynecologic Cancer Intergroup (GCIG) is an international group consisting of 33 member countries collaborating on academic research projects. ANZGOG members carry many leadership positions within this group, including Prof Alison Brand AM who serves as GCIG Chair.
ANZGOG's members are contributing to international clinical trial design more now than ever before. This is valuable, not only for ANZGOG members but also for people with a lived experience of gynaecological cancer in Australia and New Zealand, as it means that more women can participate in clinical trials, with access to a wider choice of treatments.

One of the inaugural members, ANZGOG participated in the formation of the Asia Pacific Gynecological Oncology Trials group (APGOT) in 2019. The group was formed to focus on collaborative studies in gynaecological cancer within the Asia Pacific region, strengthening capabilities and ensuring a greater range of trials available for women.
ANZGOG has already conducted two studies (MOCCA and VIP) in cooperation with Singapore as part of the OASIS Research Initiative and we look forward to more future collaborations to improve outcomes for people with a lived experience of gynaecological cancer.
More information on APGOT can be found on the following publication:
Tan D, Fujiwara N, Fujiwara K, Beale P, Kim JW, Ng J, Kim SI, Evans A, Kim BG; Asia-Pacific Gynecologic Oncology Trials Group (APGOT). The Asia-Pacific Gynecologic Oncology Trials Group (APGOT): building a Pan-Asian and Oceania women's cancer research organization. J Gynecol Oncol. 2023 Mar;34(2):e33. doi: 10.3802/jgo.2023.34.e33. PMID: 36890293; PMCID: PMC9995874. https://pubmed.ncbi.nlm.nih.gov/36890293/

ANZGOG continues to collaborate both nationally and globally with other research organisations as demonstrated in the table below:
*ANZGOG is the lead international group for this study.
ANZGOG has a long-term relationship with the NHMRC Clinical Trials Centre (CTC), at the University of Sydney, who have acted as a sponsor of our larger trials.
Strong local collaborations are fostered with institutions such as Sydney and Melbourne Universities, Walter & Eliza Hall, QIMR Berghofer Medical Research Institute, Queensland University of Technology and University of Western Australia are ensuring a diverse approach to research ideas and clinical trial development.
ANZGOG also works closely with other cooperative cancer clinical trials groups, the Quality of Life Office, CREST Health Economics to foster new trials and contribute to their development.
WomenCan is the fundraising arm of ANZGOG, funding research and education programs conducted by ANZGOG’s membership.
WomenCan’s mission is to engage with the community to fund pioneering discoveries that will enable women with gynaecological cancer to live better and live longer.

In 2023, a remarkable group of ANZGOG members, WomenCan supporters, and individuals with a lived experience of a gynaecological cancer embarked on the challenging Larapinta Trail in the Northern Territory. Over five days, they trekked rugged terrain, steep ascents, and dry riverbeds, all while surrounded by the breathtaking beauty of the West MacDonnell Ranges.
This unforgettable journey was more than just a physical challenge—it was a mission. Together, the team raised an amazing $33,396 to support ANZGOG’s gynaecological cancer research, directly contributing to better treatment options and outcomes for women.
A huge thank you to all the participants and donors who made this journey a success and helped create hope for women impacted by gynaecological cancer.
Flickering Memories, a passionate group from Burnie in North-West Tasmania, has been making a profound impact since 2020. Led by Sue Radford, who has been personally touched by women’s cancers, this dedicated team hosts annual high teas in Penguin over two days to raise funds and educate the community about the symptoms and risks of ovarian and other gynaecological cancers.
Since its inception, Flickering Memories has raised an extraordinary $57,000 for WomenCan, including $15,000 contributed in November 2023 alone to support life-saving gynaecological cancer research. The group’s heartfelt efforts culminated in funding a new ANZGOG research project, with details to be announced in December 2023.
This remarkable achievement exemplifies the power of community, reminding us of Margaret Mead’s words: “Never doubt that a small group of thoughtful, committed individuals can change the world. In fact, it’s the only thing that ever has.”
WomenCan extends its deepest gratitude to Sue Radford, the Flickering Memories team, and the entire Burnie community for their unwavering dedication and generosity.


The Venus Mother’s Day Lunch 2024 was a remarkable celebration of community, generosity, and purpose, raising over $50,000 to support WomenCan’s mission to improve the lives of women diagnosed with gynaecological cancers.
On Friday, 10 May 2024, more than 100 guests gathered at the Hyatt Regency Sydney for an intimate and inspiring event. Guests enjoyed a sumptuous grazing platter lunch accompanied by unlimited champagne, live entertainment by award-winning performer Catherine Alcorn, and a thought-provoking panel discussion titled Advancing Research Saving Lives.
The event was expertly hosted by WomenCan Ambassador Paula Duncan AM, who stepped in for Jean Kittson AM. Paula’s heartfelt connection to the cause, along with the generosity of attendees and sponsors, created a powerful sense of purpose and community.
A special thank you to our sponsors, including Platinum Sponsor NOVA Employment, Gold Sponsors Encore and Whiteley Group, and Bronze Sponsors TFO, The UGG Barn, and VDG Services, whose support made this event possible.
The Venus Community looks forward to welcoming guests later in 2024 for the annual Venus Thanksgiving Lunch. As with the Mother’s Day event, this gathering will maintain its intimate and impactful format to foster meaningful discussions and connections.


WomenCan is grateful to run Team Teal with the Harness Racing community in Australia and New Zealand, along with principal partner Tabcorp. Team Teal continues to be an important funder of ANZGOGs research and education programs, including Survivors Teaching Students. In 2024 Team Teal, through teal wins and community fundraising, raised $365,212 taking the overall total funds raised in support, since 2010 to over $3 million.
"It’s such a privilege to be chosen to wear the Team Teal colours. To be able to raise awareness and funds for such an important cause spur me on to do the best I can to help."
Kerryn Manning AM - Team Teal Ambassador




Some other wonderful partners to mention are Cure Our Ovarian Cancer, Coastal Goddess, North Sydney Bears, Oatlands Golf Club, Wild Fusion Skincare, Townsville Basketball, and the Soroptimists.
“Research costs money. Funding ensures that the best clinical trial ideas are brought to life. The only way to provide our community with access to government-funded drugs for gynaecological cancers, is to provide the clinical trial evidence that a drug works - and that costs.”

ANZGOG has collaborative agreements both locally and globally with research institutions and other clinical trial groups. It also conducts a number of its clinical trials in collaboration with the University of Sydney and its NHMRC Clinical Trials Centre (CTC). The University of Sydney supports ANZGOG with grant applications, sponsorship of agreed trials and coordination of the trial operations.
Government grant funding for the benefit of ANZGOG clinical trials projects achieved under the collaboration is administered by the University of Sydney and is received annually to support these research activities.

The Cancer Australia Support for Cancer Clinical Trials Program, provides $500,000 annually to ANZGOG to support research development work by our research staff, consumer engagement and education activities and research development workshops.